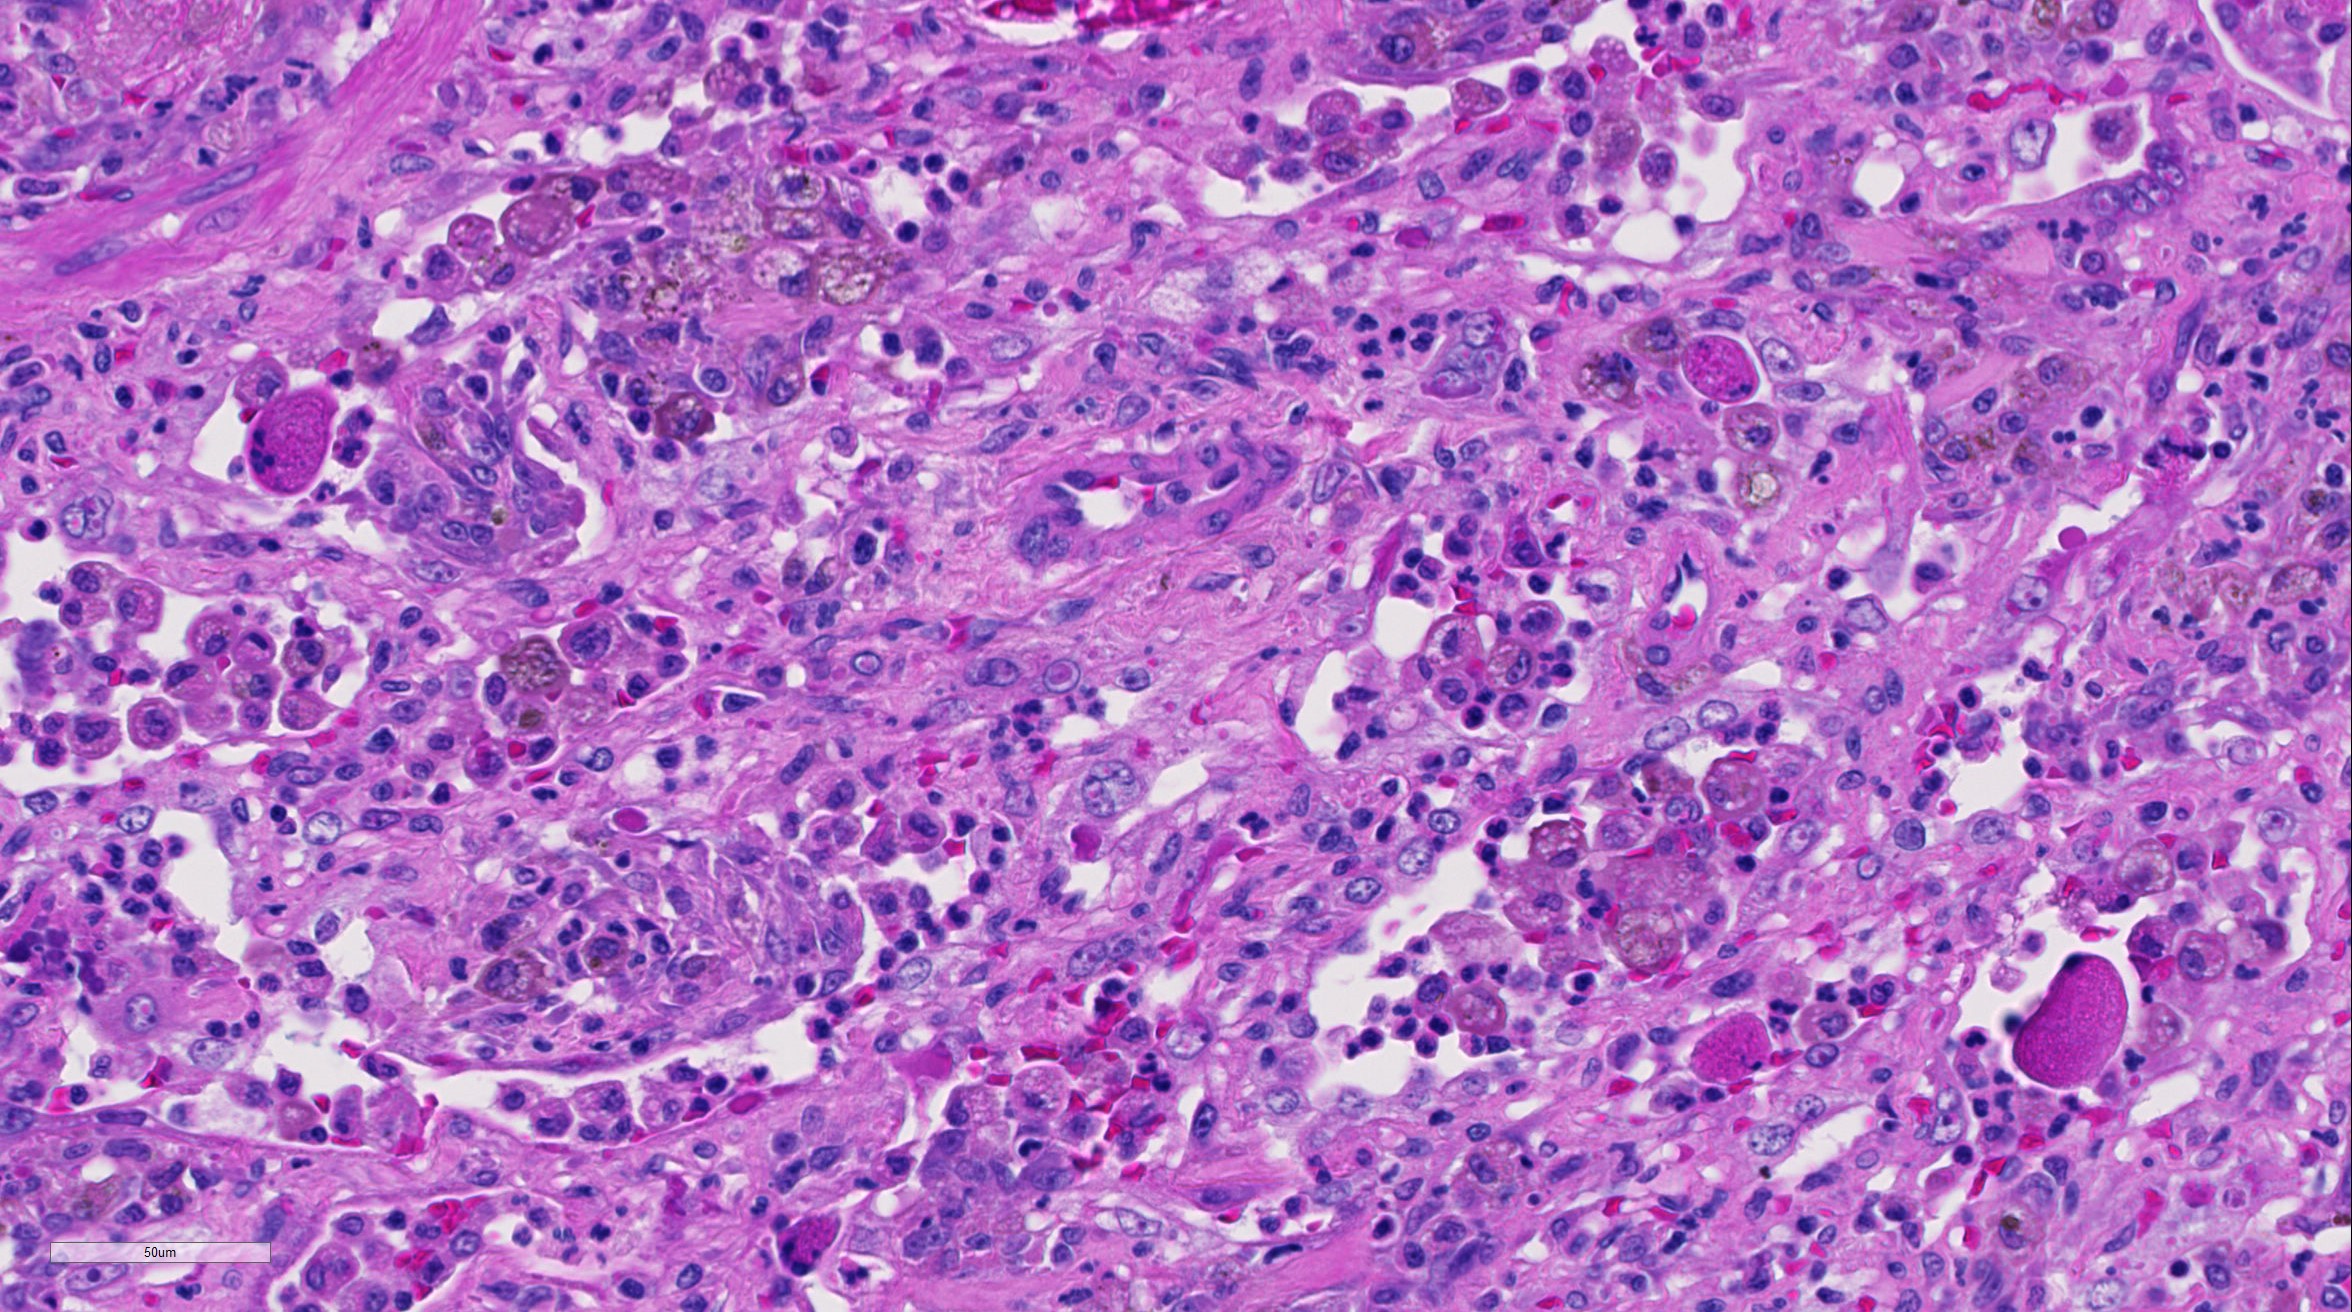
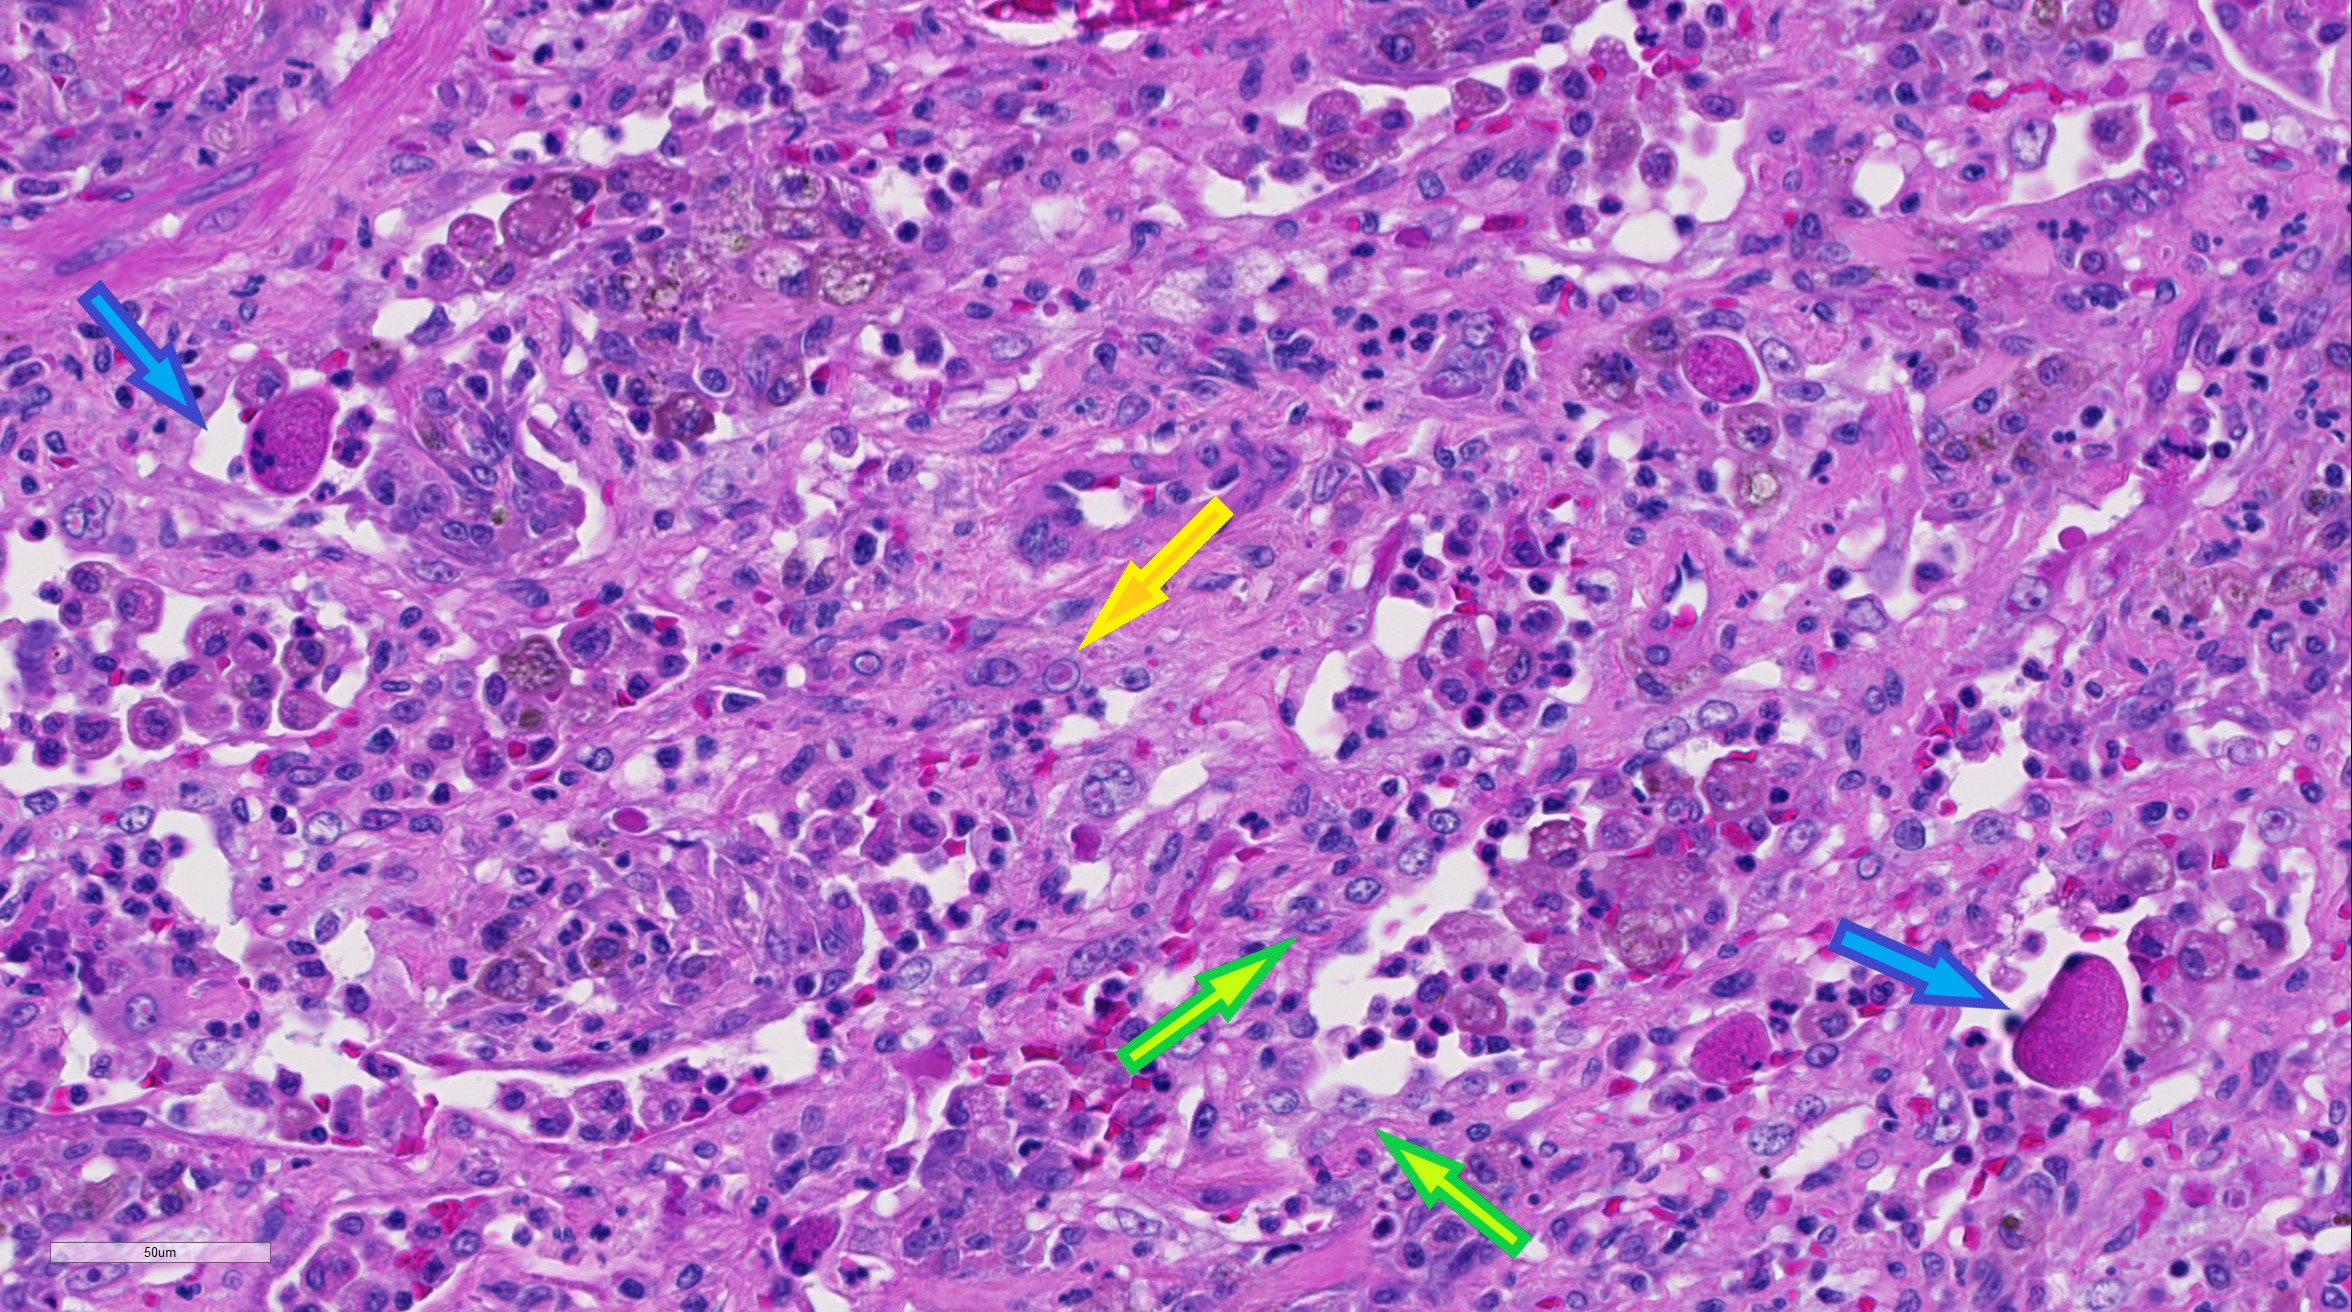

| 40X | Hematoxylin and Eosin | ||||
| Close Window | Macro View | Show Help | Back | |
|
Lung: There is alveolar type II pneumocyte hyperplasia and pneumocytes are often multinucleated with up to eight nuclei (viral syncytia) and frequently contain 4um eosinophilic intracytoplasmic and intranuclear inclusion bodies; these syncytial cells are often hypereosinophilic with karryorhectic nuclei (necrosis) and have been sloughed into alveolar lumina.
|
||||
|
||||
| Return | ||||
|
Lung: Alveolar type II pneumocyte hyperplasia (green arrows) and pneumocytes are often multi-nucleated with up to eight nuclei (viral syncytia); syncytial cells are often hypereosinophilic with karryorhectic nuclei (necrosis) and have been sloughed into alveolar lumina(blue arrows); pneumocytes (and/or macrophages) multifocally contain 4um eosinophilic intracytoplasmic and intranuclear inclusion bodies (yellow arrow).
|
||||